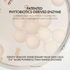

AP BEAUTY リファイニング パウダー トゥ フォーム クレンザー
通常価格
$64.60
販売価格
$64.60
通常価格
$68.00
単価
あたり
配送 チェックアウト時に計算されます。
サイズ: 55グラム
受け取り可能状況を読み込めませんでした
ギフト内容:ブースターショット M.D. セラム 5ml+パウダーフォームクレンザー 0.5g
この3ステップのパウダークレンザーは、肌のキメを整え、不純物を取り除き、その後のスキンケアのために肌に潤いを与えます。
主な成分:
特許取得済みの植物由来酵素 - 不要な角質を優しく取り除く、健康的で効果の高い酵素ピーリングです。
カオリンパウダー - 余分な皮脂や毛穴の不純物を吸収します。
ビタミンとヒアルロン酸 - 洗顔後の肌の油水分バランスを整えます。
-皮膚科医によるテスト済み
-HET-CAMテスト済み
利点
利点
使い方
使い方
材料
材料
共有:

AP BEAUTY リファイニング パウダー トゥ フォーム クレンザー
通常価格
$64.60
販売価格
$64.60
通常価格
$68.00
単価
あたり
臨床的に証明された結果
驚くべき肌効果をもたらす成分

特許取得済みの植物由来酵素

カオリン粉末
テクスチャ